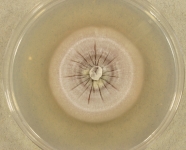

Search Details
| UAMH Number: | 7425 |
|---|---|
| Species Name: | Blastomyces percursus |
| Type: | Blastomyces percursus |
| Synonyms: | |
| Taxonomy: | FUNGI Ascomycota, Eurotiomycetes, Onygenales, Ajellomycetaceae |
| Strain History: | Polachek -> CBS -> UAMH |
| Substrate: | 53 yr old farmer in good health with granulomatous lesion on lip and ulcerated lesions on hand and soft palate; histopathology + for yeast-like cells | Location: | ISRAEL (GEO: 31.046,34.852) |
| Isolator: | I. Polachek |
| Isolation Date: | |
| Date Received: | 1993-11-19 |
| Characters: | MOLECULAR SYSTEMATICS molecular genetic variation among members of the genus Ajellomyces - Peterson & Sigler, J. Clin. Microbiol. 36:2918-2925, 1998 // SYSTEMATICS/ TAXONOMY descriptions, relationships & sexual stage of E. crescens - Sigler, J. Med. Vet. Mycol. 34:303-314, 1996 // SYSTEMATICS/ TAXONOMY phylogenetic relationships - Peterson & Sigler, J. Clin. Microbiol. 36:2918-2925, 1998 (Click for publications citing UAMH 7425) |
| Compounds: | |
| Cross Reference: | CBS 139878 // UAMH 7426 |
| Collections: | Living Strains; Dried Herbarium Material |
| Pathogenic Potential: | Human: yes | Animal: no | Plant: no |
| Biosafety Risk Group: | RG3 (check the PHAC ePATHogen Risk Group Database for updates) |
| Regulatory Requirements: | Canadian requesters must provide PHAC Pathogen and Toxin License Number (see: https://www.canada.ca/en/public-health/services/laboratory-biosafety-biosecurity/licensing-program.html) and a CFIA Written Authorization for transfer (http://www.inspection.gc.ca/plants/plant-pests-invasive-species/directives/date/d-12-03/eng/1432656209220/1432751554580#app2) prior to shipment. International requesters must provide all legally required importation documentation prior to shipment. Plant pathogenicity status may be verified by using the USDA Agricultural Research Service (ARS) Fungal Database |
| MycoBank ID: | 817662 |
| Sequences: | >UAMH07425_KY195936_bTub TCAAACCATCCCCAACCAACATCCACCCTCCTTAGTTTTCCTTGATATTATTACCTAGGGGAGCATTTGTTGTCTAACTGTTGGAACCTGTTGCTGAAATAGGGTAACCAAATTGGCGCTGCTTTCTGGTGTGTCAAAAGTCCCCTCCCCGACTACCATCCATCTCAGATATCAAGAAACATTTTGCGTGTATGCTCTGTTTACATATTTTTATACTGACAACTTTCTTCTCTTTTAAATAGGCAAAATATCTCTGGCGAGCATGGCCTCGACGGCGCCGGTTAGTAAGTGCTATAGCCAAGACTATCTATATAATTACGAAAAATCCCAGTTCCTAACTCGACATAGCTACAACGGGTCCTCTGATATCCAGCTAGAACGCATGAACGTCTACTTCAATGAGGTGGGAGAACGTTTCCCACCATTCGAGAGCAGCTGTCAGTCTACTAATAGGAATATCCCCCTTAGGCTACCGAAAAGAAATATGTCCCCCGCGCCGTCCTCGTCGACCTCGAGCCCGGCACCATGGATGCCGTCCGTGCTAGTCCCTTTGGCCAGCTTTTCCGCCCAGACAAC >UAMH07425_KY195971_LSU AACGGCGAGTGAAGCGGCAAAAGCTCAAATTTGAAATCTGGCTCCTTCGGCGCCCGAGTTGTAATTTGCAGAGGATGCTTCGGGCGTGGCCGCGGTCTAAGTCCCCTGGAACGGGGCGTCGCAGAGGGTGAGAATCCCGTCTTCGGCCGGCCGGCTTCGCCCATGTGAAGCTCCTTCGACGAGTCGAGTTGTTTGGGAATGCAGCTCTAAATGGGTGGTAAATTTCATCTAAAGCTAAATATTGGTCGGAGACCGATAGCGCACAAGTAGAGTGATCGAAAGATGAAAAGCACTTTGAAAAGAGAGTTAAACAGCATGTGAAATTGTTGAAAGGGAAGCGTTTGCGACCAGAGTCGGCCGCGGGGGTTCAGCGGGCATTCGTTGCCCGTGCACTCCCCCGCGGGCGGGCCAGCGTCGGTTTCGACGGCCGGTCAAAGGCCCCCGGAATGTGTCGCCTCTCGGGGCGTCTTATAGCCGGGGGTGCAATGCGGCCAGTCGGGACCGAGGAACGCGCTTCGGCACGGACGCTGGCTTAATGGTCGTAAGCGACCCGTCTTGAAACACGGACCAAGGAGTCTAACATCCACGCGAGTGTTCGGGTGTCAAACCCGTCCGCGCAGTGAAAGCGAACGGAGGTGGGAACCCTTAAGGGTGCACCATCGACCGATCCTGAAGTCTTCGGATGGATTTGAGTAGGAGCGTGGCTGTTGGGACCCGAAAGATGGTGAACTATGCCTGAATAGGGTGAAGCCAGAGGAAACTCTGGTGGAGGCTCGCAGCGGTTCTGACGTGCAAATCGATCGTCGAATTT >UAMH07425_KY195949_rp60S GAAAGCGATAGCAAAATTAGTATCTTGAAGGTTATACTTATACTGACTGGGATGTCAATAACAGTGTTCTTGGTGACCAGCACGATATCGATCGTGCCAAGCATCTCGGCATCGACTCCATGTCCACTGAGGACTTGAAGAAGCTGAACAAGAACAAGAAACTCATCAAGAAGCTGGCGCGCAAGTATGATGCCTTCATCGCCTCTGACAGCATCATCAAGATGGTTCCCCGTCTTTTGGGACCTGGGCTCTCTAAGGGTAAGTTTTCCCCATTTATTTTTTCTCTTCTTCAATGACCCCCTCCCACTGTTACAGGTCCATGATACAACAACCCTAACGAC >UAMH07425_KY195964_SSU-LSU CATTAACGCGCCGTGGGGGGTCGGACCCCGAAACCCGGGGAACCCCGGCCCCCTCACCTGGCCACCCTTGTCTATCTTACCTGTTGCTTCGGCGGGCCTGCAGCGATGCTGCCGGGGGAGCCTTGCTCCCCGGGCCCGTGCCCGCCGAGGACACCGCTAGAACCTCCGGTGAAACGATTGACGTCTGAGATGATAACTATAATCAGTCAAAACTTTCAACAACGGATCTCTTGGTTCCGACATCGATGAAGAACGCAGCGAAATGCGATAAGTAATGTGAATTGCAGAATTCCGTGAATCATCGAATCTTTGAACGCACATTGCGCCCTCTGGTATTCCGGGGGGCATGCCTGTCCGAGCGTCATTGCAACCCTCAAGCGCGGCTTGTGTGTTGGGCCCTCGTCCCGCCCGTGGACGTGCCCGAAATGCAGCGGCGGCGTCGTGTTCCGGTGCCCGAGCGTATGGGGCTTTGTCACCCGCTCCAGAGGCCCGGCCGGCTCCGGCCCCATCTCAACCCTTTCGGGGAAGGACGGTCTGCGGACCGGTCTCCCCAACCCAGGTTGACC >UAMH07425_AF038323_SSU-LSU AAGGATCATTAACGCGCCGTGGGGGGTCGGACCCCGAAACCCGGGGAACCCCGGCCCCCTCACCTGGCCACCCTTGTCTATCTTACCTGTTGCTTCGGCGGGCCTGCAGCGATGCTGCCGGGGGAGCCTTGCTCCCCGGGCCCGTGCCCGCCGAGGACACCGCTAGAACCTCCGGTGAAACGATTGACGTCTGAGATGATAACTATAATCAGTCAAAACTTTCAACAACGGATCTCTTGGTTCCGACATCGATGAAGAACGCAGCGAAATGCGATAAGTAATGTGAATTGCAGAATTCCGTGAATCATCGAATCTTTGAACGCACATTGCGCCCTCTGGTATTCCGGGGGGCATGCCTGTCCGAGCGTCATTGCAACCCTCAAGCGCGGCTTGTGTGTTGGGCCCTCGTCCCGCCCGTGGACGTGCCCGAAATGCAGCGGCGGCGTCGTGTTCCGGTGCCCGAGCGTATGGGGCTTTGTCACCCGCTCCAGAGGCCCGGCCGGCTCCGGCCCCATCTCAACCCTTTCGGGGAAGGACGGTCTGCGGACCGGTCTCCCCAACCCAGGTTGACCTCGGATCAGGTAGGGATACCCGCTGAACTTAAGCATATCAATAAGCGGAGGAAAAGAAACCAACAGGGATTGCCTCAGTAACGGCGAGTGAAGCGGCAAAAGCTCAAATTTGAAATCTGGCTCCTTCGGCGCCCGAGTTGTAATTTGCAGAGGATGCTTCGGGCGTGGCCGCGGTCTAAGTCCCCTGGAACGGGGCGTCGCAGAGGGTGAGAATCCCGTCTTCGGCCGGCCGGCTTCGCCCATGTGAAGCTCCTTCGACGAGTCGAGTTGTTTGGGAATGCAGCTCTAAATGGGTGGTAAATTTCATCTAAAGCTAAATATTGGTCGGAGACCGATAGCGCACAAGTAGAGTGATCGAAAGATGAAAAGCACTTTGAAAAGAGAGTTAAACAGCATGTGAAATTGTTGAAAGGGAAGCGTTTGCGACCAGAGTCGGCCGCGGGGGTTCAGCGGGCATTCGTTGCCCGTGCACTCCCCCGCGGGCGGGCCAGCGTCGGTTTCGACAGCCGGTCAAAGGCCCCCGGAATGTGTCGCCTCTCGGGGCGTCTTATAGCCGGGGGTGCAATGCGGCCAGTCGGGACCGAGGAACGCGCTTCGGCACGGACGCTGGCTTAATGGTCGTAAGCGACC >UAMH07425_KY195942_tef3 AAGATGAAGCTTGCTCTTGCCCGTGCCGTCTTCGAGGACCCTGATATCCTCCTCCTCGACGAGCCCACCAACCATCTTGACGTCAAGAACGTTCAGTGGCTCGAGAACTACCTCATCAACTCCCCTTGCACTTCCATTATCGTTTCCCACGATAGCAAGTTCTTGAACAACGTCGTCCAACACGTTATCCACTACGAACGCTTCAAGCTCCGTAGATACCGCGGCAACCTGACCGAGTTCGCCAAGCGTTGCCCATCTGCCCGCTCTTACTTCGAGCTCGGTGCCTCGGAAATGGAATTCAAGTTCCCAGAGCCAGGTTTCCTCGAAGG |
IMAGES: